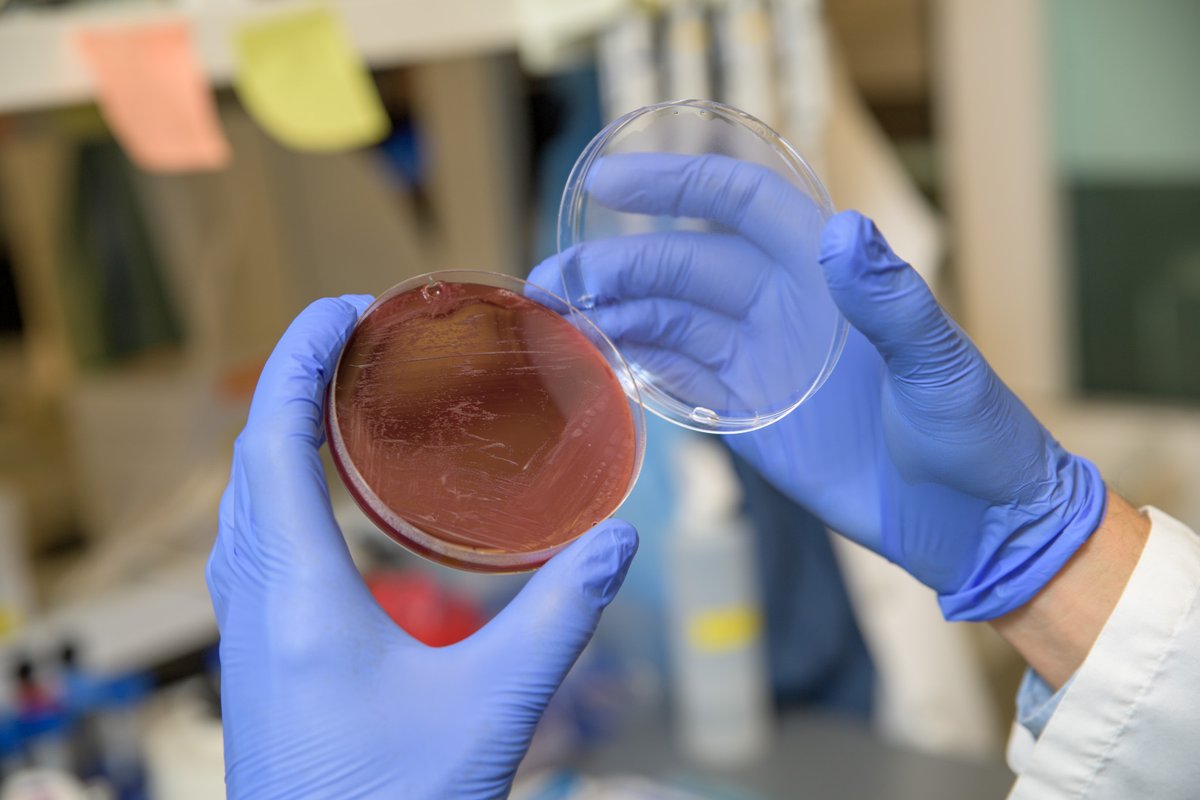
ABRC Research Profile: Dr. Paweł Łaniewski received a grant to research the impact of Sneathia on women's health. He is one of eight researchers to be awarded a grant by the Arizona Department of Health Services.

Read more on his research here: bit.ly/40lljPC

Paweł Łaniewski, PhD
@laniewskiphd
Research Scientist @uazmedphx. Bacteriologist with Interest in Host-Microbe Interactions, Microbiome, Translational Research, and Women's Health.
ID: 1189987749819895808
https://herbstkralovetzlab.weebly.com/ 31-10-2019 19:29:34
152 Tweet
159 Takipçi
240 Takip Edilen

✨Awesome day of #science at 18th Annual University of Arizona Immunopathogenesis Symposium in Tucson! So proud of my entire team of trainees lots of 1st time presenters-6 posters & 2 talks—grateful for the opportunity to share our research! ✨#proudmentor #WomensHealth #microbiome BIO5 Institute



We are delighted to announce the launch of npj Women's Health. This new open-access journal is dedicated to publishing impactful and high-quality content on all aspects of women’s health throughout the life course. Editor-in-Chief, Melissa Medvedev, MD, PhD. nature.com/npjwomenshealt…




💫 Wow—so excited & grateful our #adenomyosis poster was recognized by WES World Congress as highly commended! This work was led by Georgia May Lorentzen & Paweł Łaniewski, PhD in my lab UAZ Medicine - Phoenix and in collaboration w/Nichole Duran Mahnert MD, Dr. Leslie V. Farland, Jamal Mourad and others!💫 #WCE2023



Excellent ASRI poster session tonight and Drs. Paweł Łaniewski, PhD & Nicole Renea Jimenez representing the lab. Both are poster award 🌟 finalists! #ProudMentor #ASRI2023 #WomensHealth


Awesome evening and dinner with my team members Nicole Renea Jimenez, Paweł Łaniewski, PhD and ASRI session co-chair Dr. Anna Powell, MD MSc! #ASRI2023



Congratulations to Dr. Melissa M. Herbst-Kralovetz, PhD for receiving the J. Christian Herr Award and giving a fantastic lecture on the vaginal microbiome! #ASRI2023


Big Congratulations 👏🏼👏🏼👏🏼 to Dr.Paweł Łaniewski, PhD for being awarded 2nd place in the ASRI poster presentation competition for our work on #metabolome & #cancer! Dr. Nicole Renea Jimenez was a finalist in the competition too! #ProudMentor! #ASRI2023 #WomensHealth University of Arizona Cancer Center


My first #ASRI2023 didn’t disappoint! Top notch science 🧫 🦠 and an amazing opportunity to network with 🌎 reproductive immunologist, including a new #ASRI president, amazing @DMAronoff! 🙏 to NACP Research Education Core for supporting me to present on #endometrialcancer and #metabolomics!🥈


We have an opening for a #PhD student to uncover #nutrition #microbiome 🧫 #contaminant interactions INRAE Micalis 🇫🇷 Apply before July 1st, 2023 to join us! Please RT





IDSOG2024 dinner/dance/awards ceremony! UAB, Arizona, and LSU research teams coming together and having a blast! Melissa M. Herbst-Kralovetz, PhD lab, Jacob Elnaggar, PhD Holly Chatenoud Paweł Łaniewski, PhD Nicole Renea Jimenez “Alone we can do so little; together we can do so much.” -Helen Keller